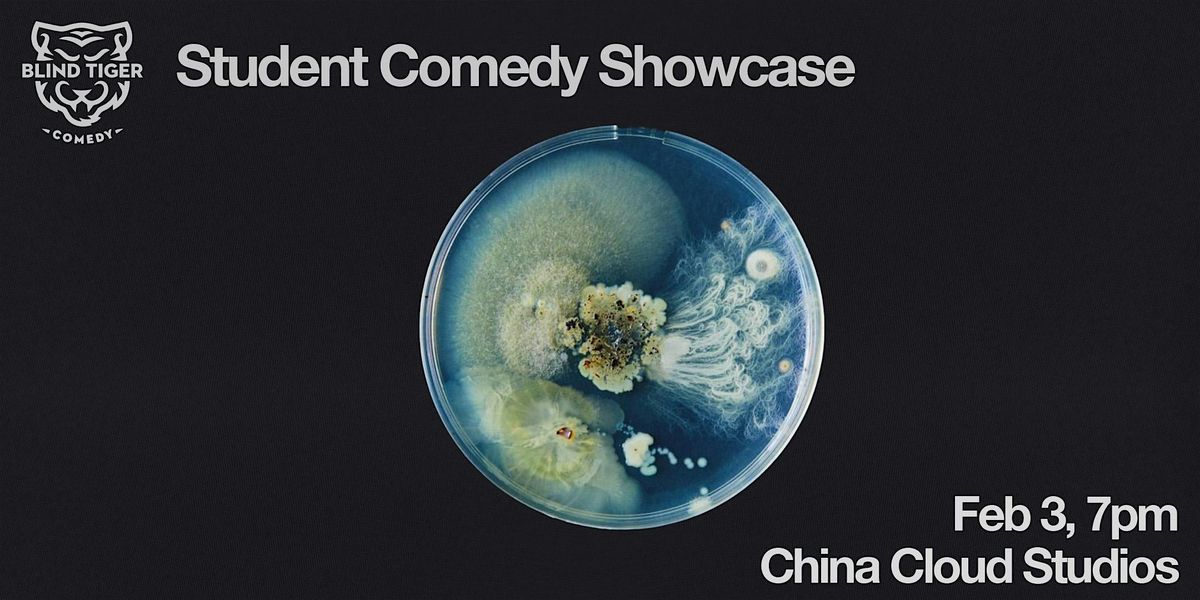

About this Event
NEED TO KNOWS
Blind Tiger Comedy Show: Fuzzy
Tuesday, February 3rd, 2025 - 7:00 PM PST
LINE UP
View tonight's line up and all other BTC show schedules here!
TICKETS
$15 or free for current BTC Students
LOCATION
China Cloud Studios - 524 Main Street.
It is on the east side of Main Street, between Pender and Keefer. Look for the address (524 Main St) above a black door with the cloud on it. For a detailed (and fun) introduction to finding the space, see our Instagram series (in the story highlights) introducing China Cloud.
Unfortunately this venue has limited accessibility due to a steep staircase at the entrance.
We are grateful to be performing on the traditional, ancestral and unceded territory of the Coast Salish Peoples, including the territories of the xwməθkwəy̓əm (Musqueam), Skwxwú7mesh (Squamish), and Səlí̓lwətaʔ/Selilwitulh (Tsleil-Waututh) Nations.
CURIOUS ABOUT CLASSES?
Check out our website! Inclusion and financial scholarships are available at all times!
Event Venue & Nearby Stays
China Cloud Studios, 524 Main Street, Vancouver, Canada
CAD 18.18











